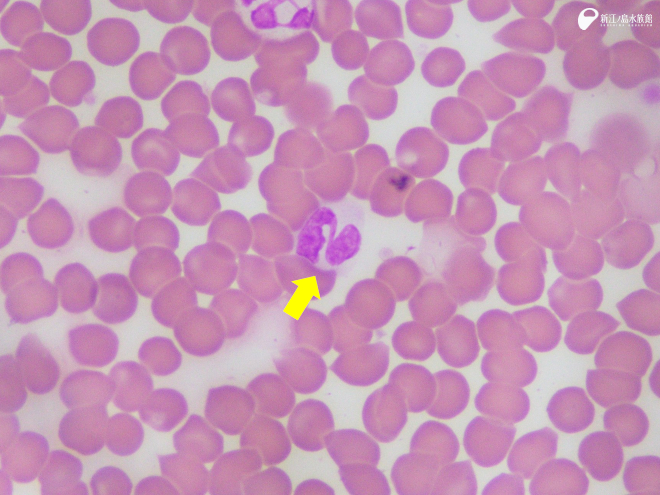
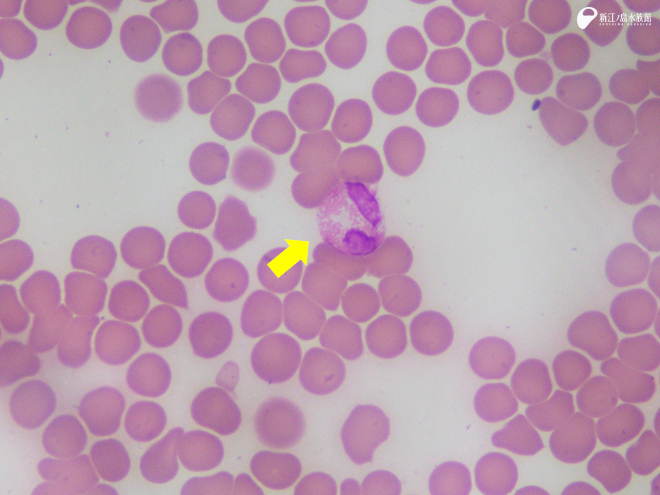
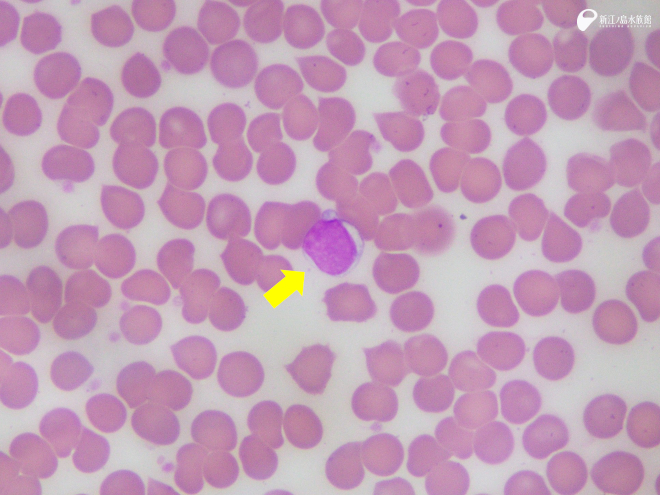
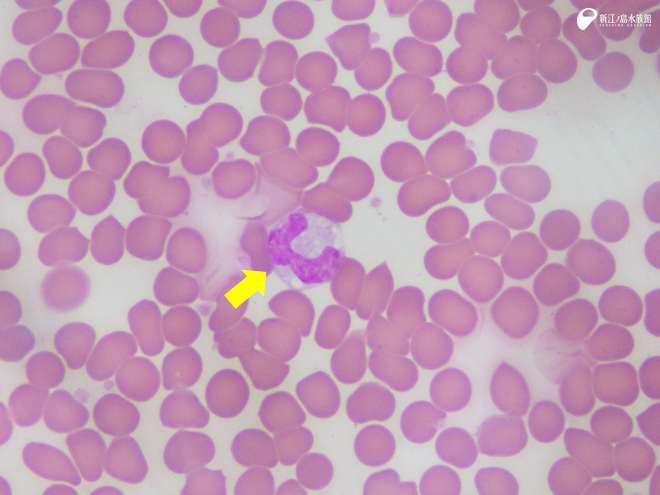

今回のタイトルは現在えのすいで開催中の、 特別イベント『えのすいで発見‼たまごっちと海のなかまたち!』 をオマージュさせていただきました。みなさん、特別イベントは楽しんでいただけていますでしょうか? 小学校の頃にアニメ見てたなー、懐かしいなーと感じている方は同世代かもしれません。私はなぜか今でもアニメのオープニングテーマが歌える、獣医師の松田です。

さて、そんな特別イベントの一環で、クラゲサイエンス横に、「たまラボ えのすい 出張所 えのたまけんびきょう」という展示があります。顕微鏡を使ったお世話もする、えのすいトリーターの気分が体験できる、すてきな展示になっているのですが、ここの「イルカの血液検査」の部分は、私たちえのすい医療チームが少し監修させてもらいました。
血液をズームしていくと赤血球や白血球が見えてきて、白血球にもいろいろな種類がいるんだよーということを紹介しているのですが…。私としては、この展示だけではまだ白血球たちについて語り尽くせない! ということで、今回は展示でご紹介したイルカではなく、ゴマフアザラシの血液の顕微鏡写真を使って、白血球のなかまたちについて詳しく解説します。なお、これから出てくる白血球の写真は、特殊な液体を使って核や細胞質に色を付ける染色をおこなっています。本物の血液の中だとこんな色ではないよ!

まずこちら、好中球(こうちゅうきゅう)です。白血球の中でも主要なメンバーで、細菌などの病原体が体内に侵入した場合に、いち早く駆けつけて対処する、切り込み隊長のような役割をしています。見た目の特徴は、節に分かれたような核(濃い紫色の部分、分葉核とも言います)があり、そのまわりの細胞質はあまり染まりません。
核の分葉の数は、若い好中球ほど少なく、成熟するにつれて増えてきます。この好中球全体の分葉の程度によって、炎症が急性のものなのか、ある程度時間がたったものなのかを判断する材料にもなります。
次に好酸球(こうさんきゅう)。こちらは主に寄生虫感染が起きた場合に動員されたり、ある種のアレルギー反応が起きた時に増えることが知られています。核の形は好中球に似ているのですが、細胞質の中にピンク色のつぶつぶ、顆粒が見えるのが特徴です。酸性の色素に染まりやすい顆粒を持つことから、好「酸」球の名前が付いています。
好酸球とは違い、細胞質に濃い紫色の顆粒を持つ好塩基球(こうえんききゅう)も存在するのですが、血液中の数が少ない種類で、今回は写真を撮影することができませんでした…。普段の検査でもめったに見ることはありません。好塩基球もアレルギー反応に関わる細胞です。
こちらはリンパ球です。好中球と並ぶ主要な白血球で、リンパ球は病原体との戦いの後半に活躍します。敵に合わせて抗体という武器を作り出し、戦いを有利に進められるようにする頭脳派です。先ほどの 3種類とは違い、核が丸いのが特徴で、核に対して細胞質が狭いです。
最後は、白血球の中ではサイズが最も大きい単球(たんきゅう)です。他の白血球に比べて核の色は淡く、典型的なものは馬てい形をしていますが、わりといろいろな形になります。細胞質もリンパ球に比べれば広めです。好中球と同じように病原体と直接戦うだけでなく、戦いの後に出てきてしまった不要なものも処理してくれます。さまざまな組織に出向いて行って、それぞれ特異的な働きをしたりもします。
以上の 5種類に白血球は大きく分類できます。
この白血球の中でどの種類が増えているかや、数がどう変化するかを調べることで、病気の診断をしています。例えば感染症の初期では、切り込み隊長の好中球、特に分葉の少ない好中球が多くなり、終盤や慢性化した時にはリンパ球が増えていたりなどです。
血液の中には白血球だけではなく、酸素を運搬する赤血球や出血を止める働きをする血小板という細胞もいます。もっと細かく見ていけば、細胞の中にすらエネルギーを生み出すミトコンドリア、タンパク質を合成するリボソームなどなど、たくさんの器官があり、これらの小さな「なかまたち」の働きで私たちは動いているのです。
たまごっちたちのたまさいぼーのように、私たちのからだをズームしていったら、面白いものが見られるかもしれませんね。